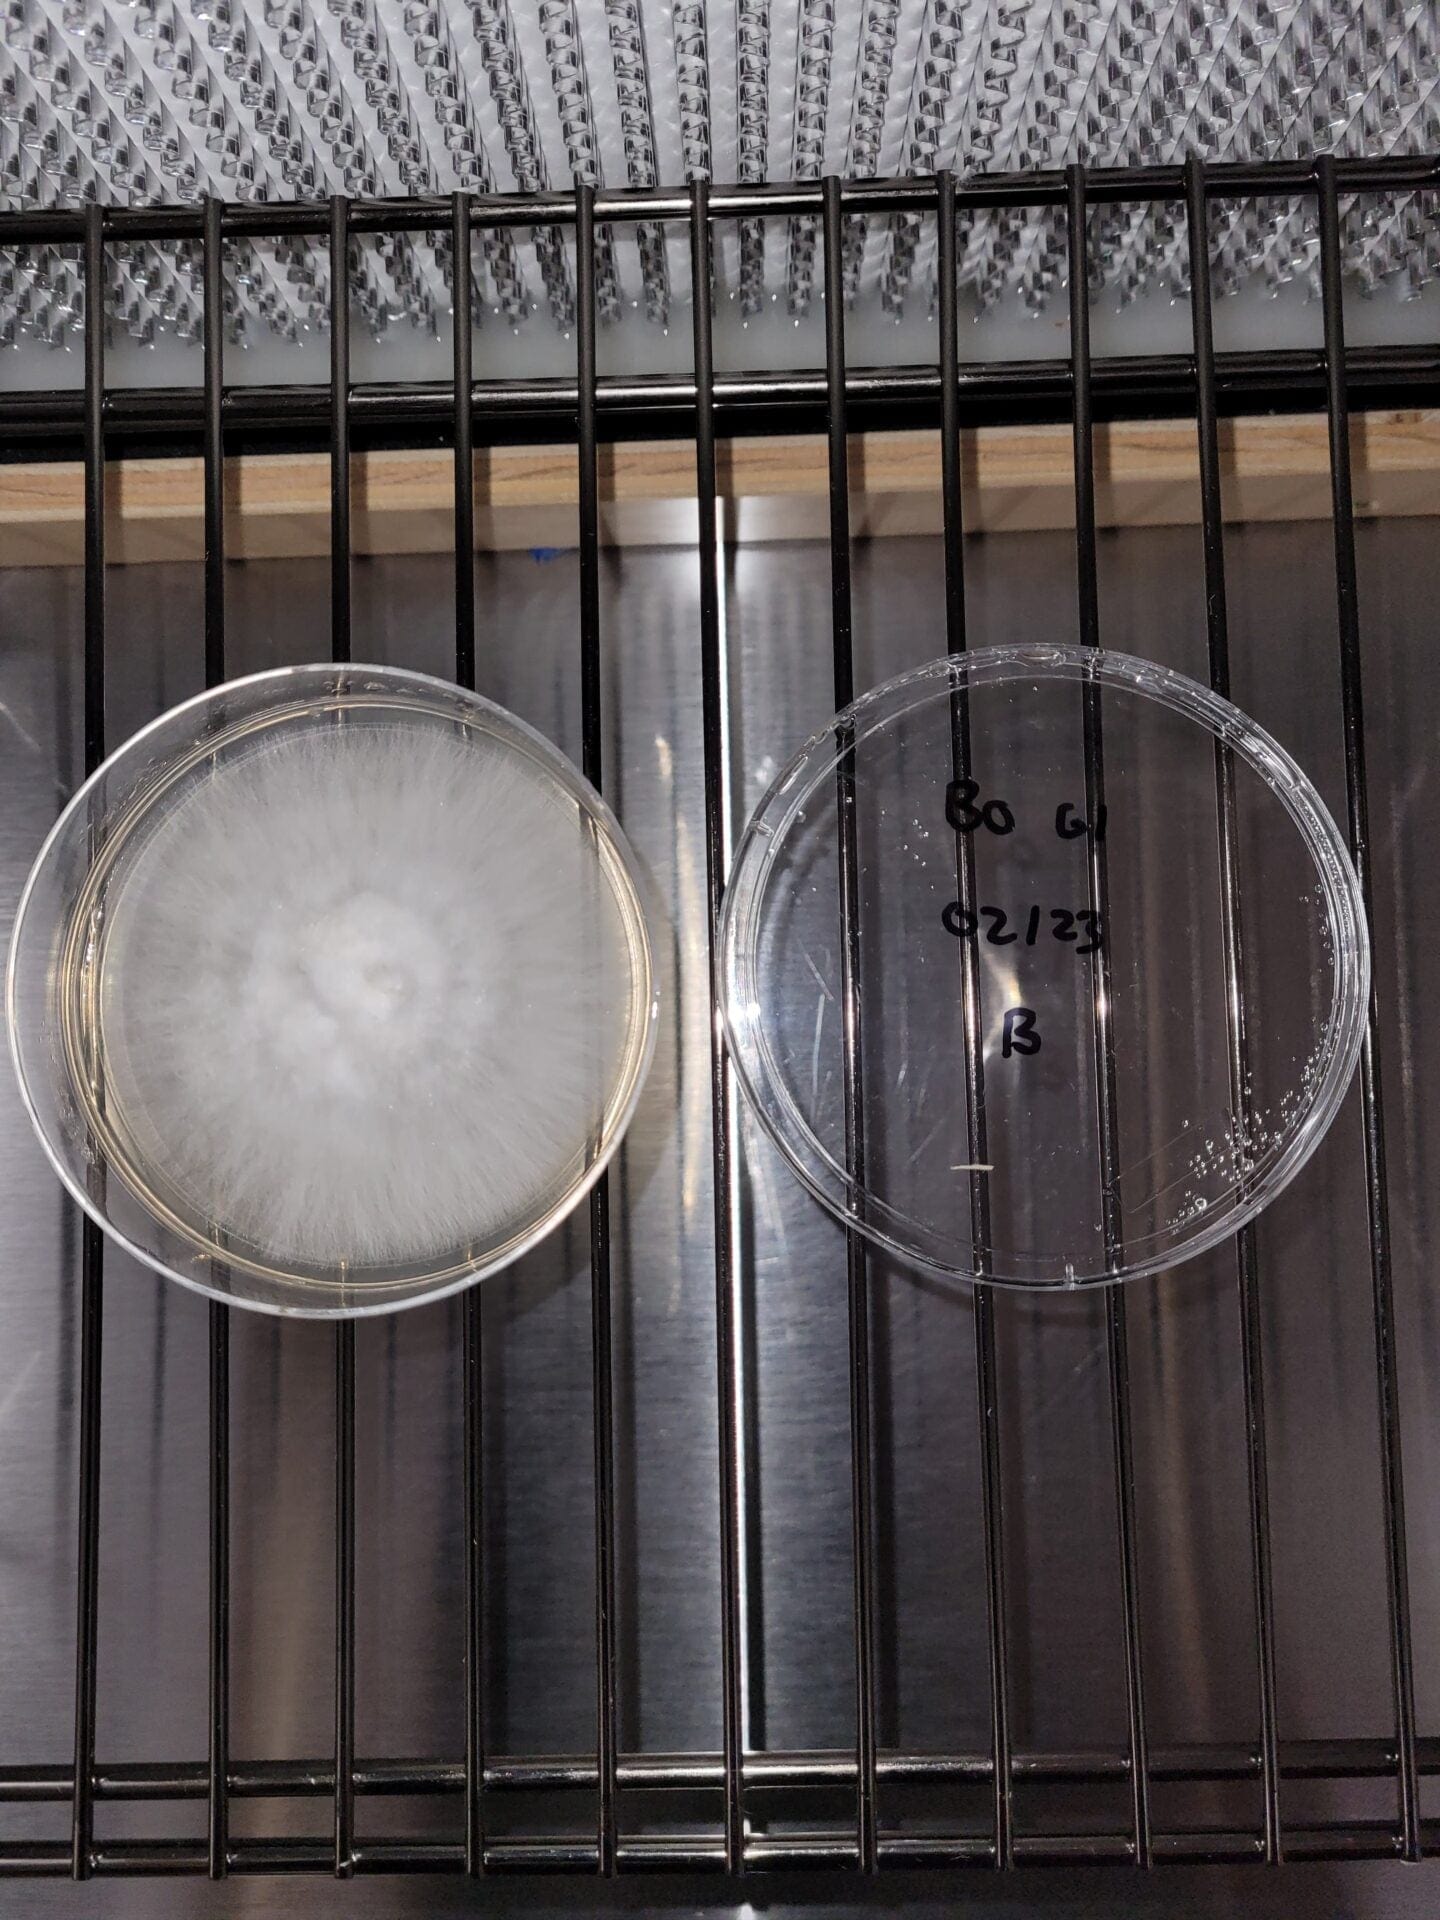

Circular Harvest
Blue Oyster (Pleurotus ostreatus columinus) Agar Culture
Blue Oyster (Pleurotus ostreatus columinus) Agar Culture
Couldn't load pickup availability
Blue Oyster mushrooms (Pleurotus ostreatus columinus) are a common culinary mushroom that usually grow in large "shelf-like" clusters. Pleurotus mushrooms are among the fastest fruiting mushrooms known to man, and when conditions are right clusters can double in size within a day! These mushrooms also have uses beyond the kitchen, and are commonly used for industrial-scale mycoremediation purposes.
The Blue Oyster mushroom is widespread in many temperate and subtropical forests throughout the world, and is a saprotroph that acts as a primary decomposer of wood, especially hardwood trees. Therefore, when growing Oyster mushrooms indoors one must use a hardwood-amended substrate.
Adding this agar culture to our sterilized rye grain will produce high quality grain spawn that can be used to inoculate a wood based sterilized substrate.
The Blue Oyster isolate is grown from spore and kept viable using tissue culturing techniques. We grow it on agar in a parafilm-wrapped 90x20mm petri dish. Our agar is made with agar agar powder which is food grade with a high gel strength of 900g/cm2. We add light dry malt extract powder to our agar mixture to help promote growth of the mycelium.
Share